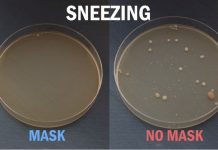
Khẩu trang vải hay khẩu trang y tế đều có khả năng chống virus Khẩu trang vải hay khẩu trang y tế đều có khả năng chống virus - Ảnh 1.

Thẻ: tình hình dịch bệnh
Doanh nghiệp kiệt quệ vì hủy, hoãn tour, Hiệp hội Du lịch tha thiết...
Từ khi dịch bùng phát lần 3, tất cả đoàn du lịch ra miền Bắc của các doanh nghiệp lữ hành ở TP.HCM phải...
Khẩu trang vải hay khẩu trang y tế đều có khả năng chống virus
VTV.vn - Khi tình hình dịch bệnh đang trở lại với diễn biến phức tạp, chiếc khẩu trang phần nào giúp chúng ta tránh...
Hy Lạp dự kiến cho phép khách sạn mở cửa trở lại trước tháng...
VTV.vn - Sau thời gian phong tỏa, Hy Lạp đã bắt đầu tái hoạt động các loại hình dịch vụ trong nước, với mục...